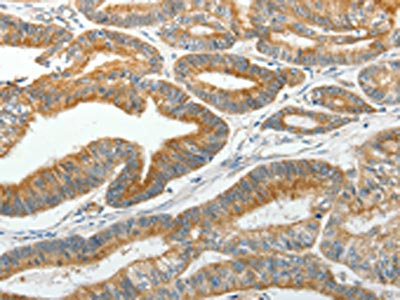

SLC12A4 Antibody
-
中文名稱:SLC12A4兔多克隆抗體
-
貨號:CSB-PA572733
-
規(guī)格:¥1100
-
圖片:
-
The image on the left is immunohistochemistry of paraffin-embedded Human thyroid cancer tissue using CSB-PA572733(SLC12A4 Antibody) at dilution 1/30, on the right is treated with fusion protein. (Original magnification: ×200)
-
The image on the left is immunohistochemistry of paraffin-embedded Human colon cancer tissue using CSB-PA572733(SLC12A4 Antibody) at dilution 1/30, on the right is treated with fusion protein. (Original magnification: ×200)
-
-
其他:
產(chǎn)品詳情
-
Uniprot No.:
-
基因名:SLC12A4
-
別名:Electroneutral potassium chloride cotransporter 1 antibody; Electroneutral potassium-chloride cotransporter 1 antibody; Erythroid K Cl cotransporter 1 antibody; Erythroid K-Cl cotransporter 1 antibody; FLJ40489 antibody; hKCC 1 antibody; hKCC1 antibody; KCC 1 antibody; KCC1 antibody; Potassium transport protein antibody; Potassium/chloride cotransporter 1 antibody; S12A4_HUMAN antibody; Slc12a4 antibody; Solute carrier family 12 (potassium/chloride transporters) member 4 antibody; Solute carrier family 12 member 4 antibody
-
宿主:Rabbit
-
反應(yīng)種屬:Human,Mouse,Rat
-
免疫原:Fusion protein of Human SLC12A4
-
免疫原種屬:Homo sapiens (Human)
-
標(biāo)記方式:Non-conjugated
-
抗體亞型:IgG
-
純化方式:Antigen affinity purification
-
濃度:It differs from different batches. Please contact us to confirm it.
-
保存緩沖液:-20°C, pH7.4 PBS, 0.05% NaN3, 40% Glycerol
-
產(chǎn)品提供形式:Liquid
-
應(yīng)用范圍:ELISA,IHC
-
推薦稀釋比:
Application Recommended Dilution ELISA 1:2000-1:5000 IHC 1:50-1:200 -
Protocols:
-
儲存條件:Upon receipt, store at -20°C or -80°C. Avoid repeated freeze.
-
貨期:Basically, we can dispatch the products out in 1-3 working days after receiving your orders. Delivery time maybe differs from different purchasing way or location, please kindly consult your local distributors for specific delivery time.
-
用途:For Research Use Only. Not for use in diagnostic or therapeutic procedures.
相關(guān)產(chǎn)品
靶點(diǎn)詳情
-
功能:Mediates electroneutral potassium-chloride cotransport when activated by cell swelling. May contribute to cell volume homeostasis in single cells. May be involved in the regulation of basolateral Cl(-) exit in NaCl absorbing epithelia. Isoform 4 has no transport activity.
-
基因功能參考文獻(xiàn):
- data indicate that Zn(2+) acting via ZnR/GPR39 has a direct role in controlling Cl(-) absorption via upregulation of basolateral KCC1 in the colon. Moreover, colonocytic ZnR/GPR39 and KCC1 reduce water loss during diarrhea and may therefore serve as effective drug targets. PMID: 28093242
- Insulin-like growth factors I can induce the upregulation of KCC1 gene, and KCC1 gene participates in the invasion ability of HEC-1B cells through the ERK signaling pathway. PMID: 21666489
- KCC3 is the dominant isoform in erythrocytes, with variable expression of KCC1 and KCC4 that could result in modulation of KCC activity PMID: 21733850
- human osteoblasts express functional K-Cl cotransporters in their cell membrane that seem to be able to induce the indirect activation of volume-sensitive Cl- channels by KCl through an increase in intracellular ions, water influx and cell swelling. PMID: 12637262
- loss-of-function KCC mutant cervical cancer cells exhibit inhibited cell growth accompanied by decreased activity of cell cycle gene products PMID: 12902337
- the KCC1 gene promoter lacks a TATA box and is composed of an initiator element (InR) and a downstream promoter element (DPE) PMID: 14976052
- Hb polymerisation and sickling could be dissociated from the abnormal response of KCC to deoxygenation observed in HbS-containing red cells. PMID: 15039017
- KCC activation by IGF-1 plays an important role in IGF-1 signaling to promote growth and spread of gynecological cancers. PMID: 15262997
- IGF-II (insulin-like growth factors-2) can enhance KCC1 (KC1 co-transport-1) gene expression in cervical cancer cells through signal transduction pathways PMID: 19317253
顯示更多
收起更多
-
亞細(xì)胞定位:Membrane; Multi-pass membrane protein.
-
蛋白家族:SLC12A transporter family
-
組織特異性:Ubiquitous. Levels are much higher in erythrocytes from patients with Hb SC and Hb SS compared to normal AA erythrocytes. This may contribute to red blood cell dehydration and to the manifestation of sickle cell disease by increasing the intracellular con
-
數(shù)據(jù)庫鏈接:
Most popular with customers
-
-
YWHAB Recombinant Monoclonal Antibody
Applications: ELISA, WB, IHC, IF, FC
Species Reactivity: Human, Mouse, Rat
-
Phospho-YAP1 (S127) Recombinant Monoclonal Antibody
Applications: ELISA, WB, IHC
Species Reactivity: Human
-
-
-
-
-